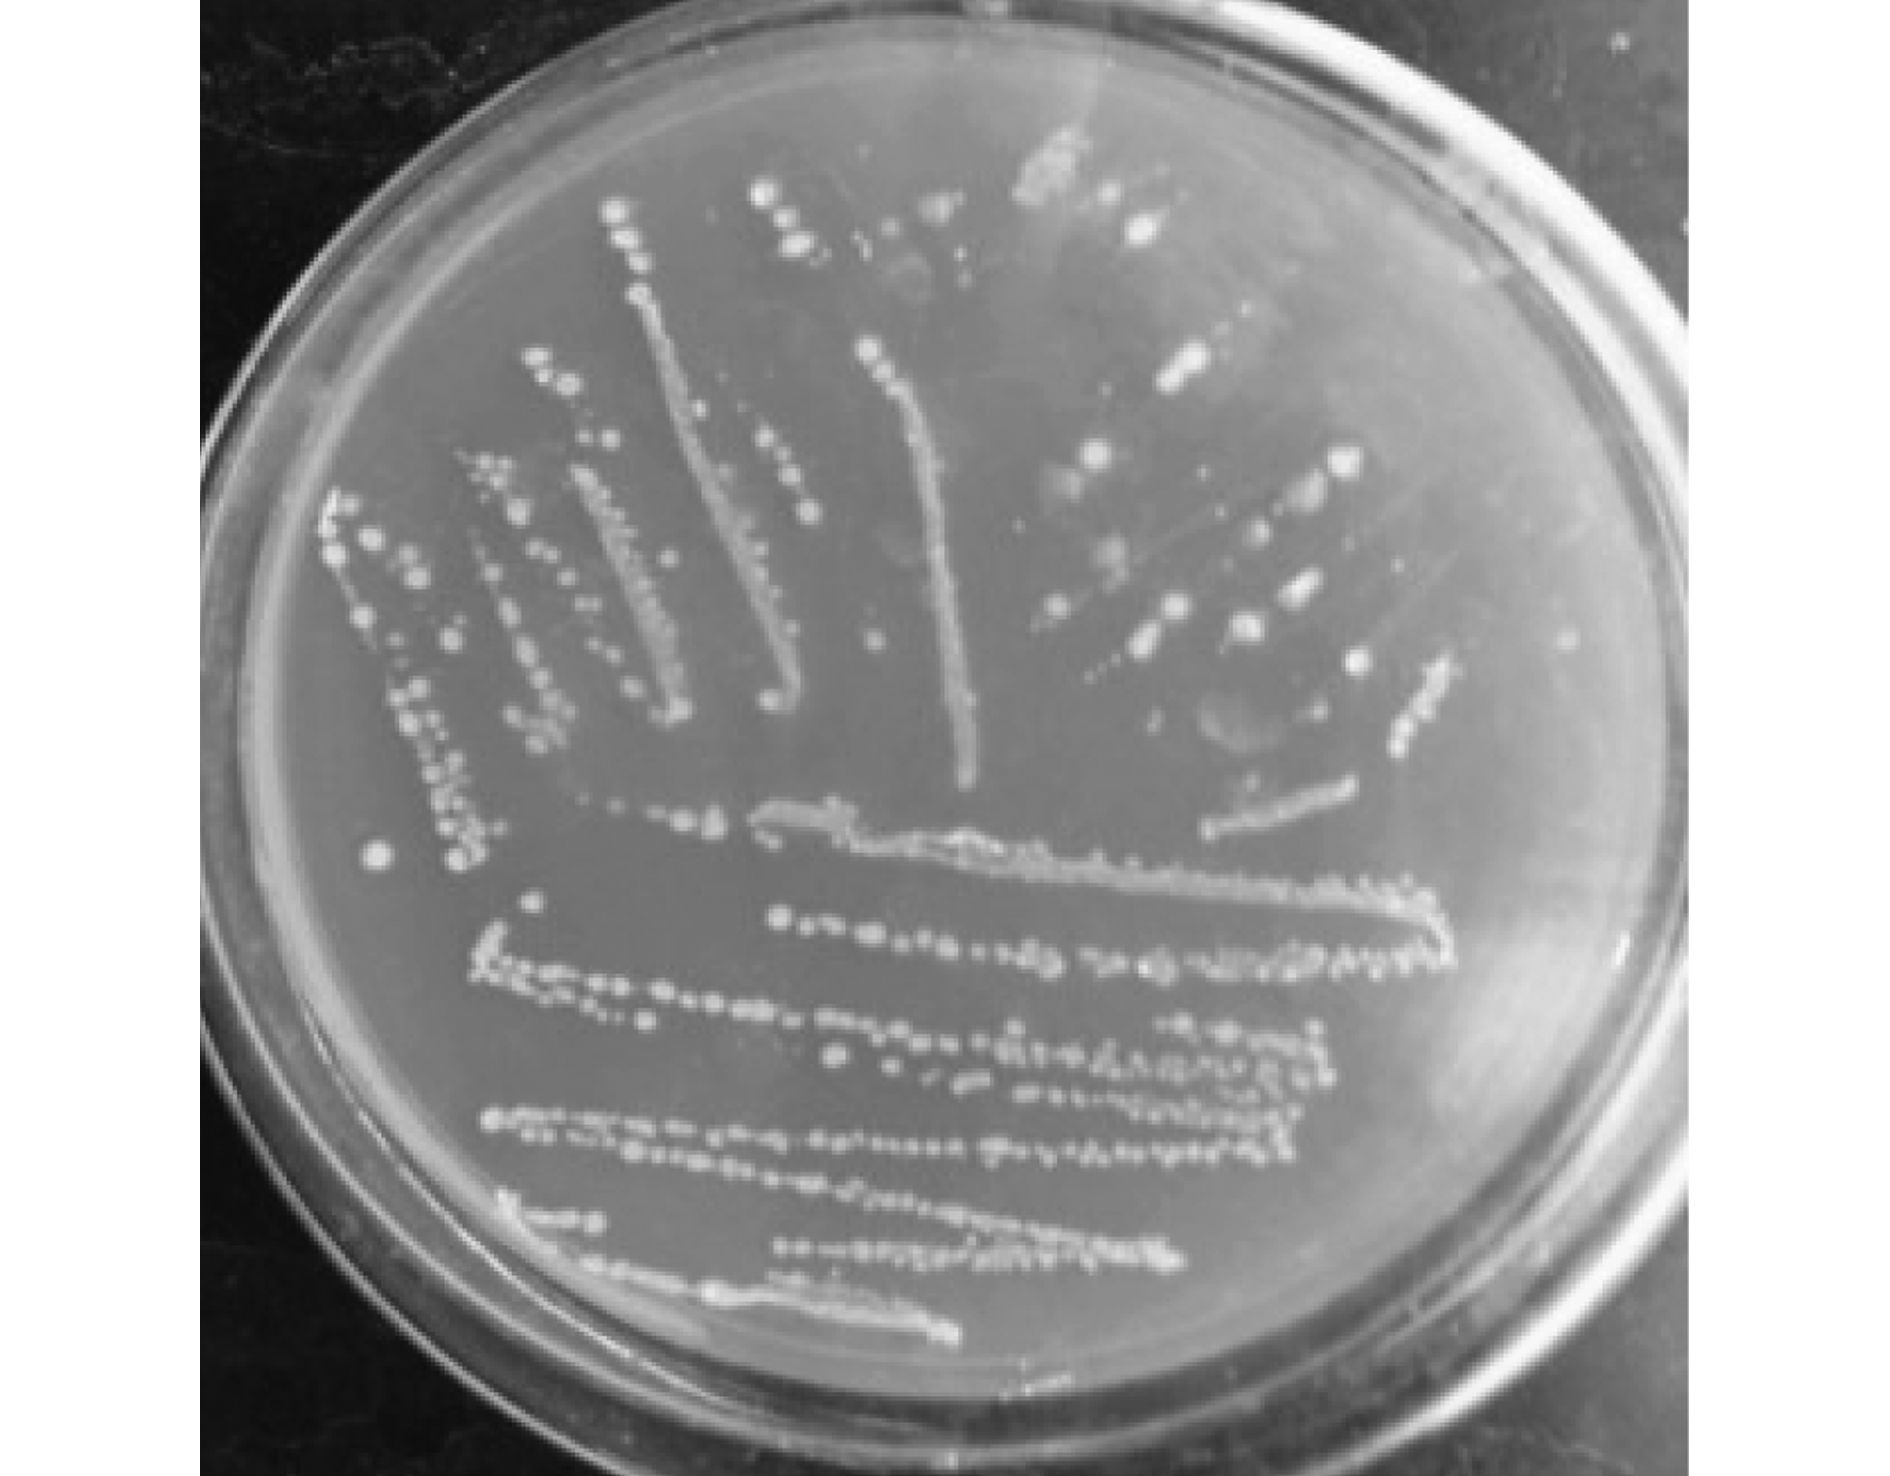

內(nèi)蒙古自治區(qū)東北部、 遼寧與吉林省西部、 黑龍江省大部等嚴(yán)寒村鎮(zhèn)近65%的生活用水取自地下,2014年針對黑龍江省18個村鎮(zhèn)分散地下水質(zhì)進(jìn)行監(jiān)測,發(fā)現(xiàn)受原生地質(zhì)環(huán)境與地層錳礦影響,冬季村鎮(zhèn)地下水Fe2+、 Mn2+濃度范圍分別為0.44~20.4 mg·L-1、 0.65~2.55 mg·L-1,屬于典型的高鐵錳地下水,按《地下水環(huán)境質(zhì)量標(biāo)準(zhǔn)(GB 3838-2002)》中Ⅲ類水標(biāo)準(zhǔn)進(jìn)行評價,F(xiàn)e2+、 Mn2+濃度超標(biāo)嚴(yán)重,最大超標(biāo)倍數(shù)分別達(dá)67、 24.5倍,嚴(yán)重威脅村鎮(zhèn)經(jīng)濟(jì)發(fā)展與人民群眾身體健康,研發(fā)嚴(yán)寒村鎮(zhèn)高鐵錳飲用水凈化技術(shù)具有重要現(xiàn)實意義.
生物法作為地下水除鐵錳的熱點研究方法,雖在工藝及微生物方面均取得了一定的成績,但以下問題亟待解決: ①嚴(yán)寒村鎮(zhèn)地下水處于低溫環(huán)境,低溫條件下微生物面臨活性低、 濾層培養(yǎng)成熟緩慢、 處理效果不佳等難題,因此如何克服低溫影響,實現(xiàn)鐵、 錳低溫環(huán)境下的有效去除已成為飲用水處理領(lǐng)域共同關(guān)注的瓶頸問題.②目前除鐵錳菌大都局限于細(xì)菌形態(tài)觀察、 分離、 純化與鑒定.探究高效除鐵錳菌的接種方式及其應(yīng)用效能,將為生物除鐵錳濾池的構(gòu)建與快速啟動提供有力的技術(shù)支持.③生物濾池除鐵錳涉及濾料吸附作用、 生物菌氧化作用及鐵錳氧化物的自催化作用,但各自作用的貢獻(xiàn)率還有待進(jìn)一步明確.
本研究將以碳化稻殼顆粒為基質(zhì),篩選優(yōu)勢鐵錳氧化菌,耦合凈化嚴(yán)寒村鎮(zhèn)地下水中鐵錳; 并優(yōu)選載銀活性炭顆粒去除生物碳化稻殼濾柱處理后的殘余菌,保證飲用水安全; 探究裝置低溫快速啟動方式,探討生物濾層內(nèi)鐵錳氧化去除機(jī)制; 該研究將為嚴(yán)寒村鎮(zhèn)高鐵錳地下飲用水處理技術(shù)開發(fā)提供理論依據(jù),具有重要學(xué)術(shù)價值.
1 材料與方法 1.1 試驗裝置與試驗用水
試驗裝置見圖 1,包括曝氣池、 菌液池、 兩個濾柱、 中間水池與出水池.濾柱Ⅰ、 Ⅱ直徑80 mm,自上至下依次添裝1 300~1 500 mm高濾料與80~100 mm高鵝卵石與錳砂混合承托料,濾柱Ⅰ、 Ⅱ濾料分別為碳化稻殼顆粒(CRH600,20~120目,自制[4])與載銀活性炭顆粒(5~10 目,購自東莞市樟木頭楓林活性炭有限公司),濾柱Ⅱ用于去除濾柱Ⅰ出水的殘余鐵錳與生物菌.試驗水溫通過制冷機(jī)控制在17℃(此溫度設(shè)定主要考慮鐵錳氧化菌的活性).

圖 1 試驗裝置示意
試驗用水為靜置24 h以上的自來水配制的FeSO4與MnSO4混合溶液,控制Fe2+、 Mn2+質(zhì)量濃度分別為3.95~18.54 mg·L-1、 0.57~2.28mg·L-1,pH值為6.8~7.2; 濾柱Ⅰ采用跌水曝氣,控制[O2]為4~5 mg·L-1.
1.2 優(yōu)勢菌種與菌懸液
從黑龍江省哈爾濱市紅旗農(nóng)場地下水井周圍采集泥樣,經(jīng)菌株分離初篩復(fù)篩與16S rDNA測序分析,確定對鐵錳降解率最高的優(yōu)勢菌株歸屬于巨大芽孢桿菌 (Bacillus megaterium,GenBank登錄號為KP241857).該菌株在培養(yǎng)基中的菌落形態(tài)如圖 2所示.
圖 2 巨大芽孢桿菌的菌落形態(tài)
將Bacillus megaterium菌株接種于錐形瓶(盛有5mL PYCM改良培養(yǎng)基)中,17℃搖床活化12 h,轉(zhuǎn)速125 r·min-1,取活化后的菌液2 mL于200 mL PYCM改良培養(yǎng)基中,以同樣條件培養(yǎng)24h至對數(shù)生長末期,培養(yǎng)液離心(4 500 r·min-1,10 min)收集菌體,無菌生理鹽水洗滌3次,重懸于HEPES緩沖液(pH 7.0),制備菌懸液,確定菌濃度(平板稀釋計數(shù)法),進(jìn)而配制試驗所需的4.0×109CFU·mL-1菌懸液.其中,PYCM改良培養(yǎng)基成分如下: 蛋白胨0.5 g,葡萄糖0.3 g,酵母浸膏0.2 g,MnSO4·H2O 0.2 g,K2HPO4 0.1 g,MgSO4·7H2O 0.2 g,NaNO3 0.2 g,CaCl2 0.1 g,(NH4)2CO3 0.1 g,檸檬酸鐵銨0.8 g,定容至1 000 mL,pH值6.8~7.2.
1.3 分析項目與測定方法
根據(jù)文獻(xiàn),進(jìn)出水Fe2+、 Mn2+、 菌濃度的測定分別采用鄰菲羅啉分光光度法、 高碘酸鉀氧化分光光度法、 平板法,F(xiàn)e2+、 Mn2+質(zhì)量濃度標(biāo)準(zhǔn)曲線方程分別為y=0.182 8x-0.007 5(R2=0.999 6)、 y=0.038 3x+0.004 4 (R2=0.999 1).
1.3.1 裝置啟動與穩(wěn)定運(yùn)行研究分析
裝置啟動初期,為評價生物菌除鐵錳作用,將高濃度4.0×109 CFU·mL-1鐵錳氧化菌液注入鐵錳吸附飽和的碳化稻殼濾柱Ⅰ中,浸泡1 d,控制濾速2 m·h-1,循環(huán)運(yùn)行4 d,在7、 13、 19 d分別將濾速提高至3、 4、 5 m·h-1,反沖洗強(qiáng)度相應(yīng)提高至4、 6、 8 L·(s·m2)-1,反沖洗周期2 d(3 min),在無培養(yǎng)基、 低營養(yǎng)源的條件下,利用地下水自身營養(yǎng),低濾速馴化培養(yǎng)富集功能菌群,根據(jù)出水鐵錳濃度,分析濾柱Ⅰ的快速啟動.第25 d,進(jìn)出水暫停,濾柱Ⅰ被進(jìn)水浸泡6 d,待第32 d以2 m·h-1濾速低速啟動,考察濾柱抗沖擊能力與穩(wěn)定性.濾柱Ⅱ控制濾速5 m·h-1,反沖洗強(qiáng)度8 L·(s·m2)-1,反沖洗周期2 d(3 min),考察濾柱Ⅱ進(jìn)出水鐵錳質(zhì)量濃度與細(xì)菌濃度.穩(wěn)定運(yùn)行階段后期,若濾層表面出現(xiàn)鐵泥板結(jié)、 輕微裂縫現(xiàn)象,反沖洗周期、 強(qiáng)度、 時間分別取24 h、 10 L·(s·m2)-1、 5 min.
1.3.2 Fe2+去除機(jī)制分析
待濾柱Ⅰ啟動成功后,基于接觸氧化法與生物法,對比分析不同濾速條件下濾柱Ⅰ每d各濾層沿程(自上而下20、 40、 60、 80、 100、 120、 140 cm)出水的總鐵、 Fe2+濃度及反應(yīng)速率,考察除鐵機(jī)制.設(shè)定反沖洗強(qiáng)度、 時間、 周期分別為10 L·(s·m2)-1、 2 min、 2 d,進(jìn)水總鐵濃度分別為2、 5、 10 mg·L-1,濾速分別為3m·h-1、 5m·h-1,濾速固定時,濾柱Ⅰ在每個進(jìn)水總鐵濃度下運(yùn)行7 d.
1.3.3 Mn2+去除機(jī)制分析
采用SEM表征濾柱成功啟動后30 cm深度處濾料表面與反沖洗泥樣的微生物及鐵錳氧化物附著情況.采用FTIR對原始碳化稻殼與成熟濾料進(jìn)行分析,進(jìn)一步確定濾料表面附著的片層狀或顆粒結(jié)構(gòu)物質(zhì).采用XPS對反沖洗泥樣進(jìn)行分析,明確濾料表面元素價態(tài).采用Raman光譜分析不同運(yùn)行時間條件下濾柱中30cm深度處的濾料,明確MnOx的物相組成.自濾柱成功啟動(15d)后對不同運(yùn)行時間的濾料表面與反沖洗中的水鈉錳礦進(jìn)行EPR分析,明確Mn2+去除機(jī)制.
2 結(jié)果與討論 2.1 培養(yǎng)與穩(wěn)定階段的運(yùn)行情況
向濾柱Ⅰ投加大量菌種后,循環(huán)往復(fù)供給優(yōu)勢菌液,利于鐵錳優(yōu)勢菌株接種于濾料表面且生長繁殖,接種后需對細(xì)菌進(jìn)行低溫、 貧營養(yǎng)等自然選擇馴化,濾柱Ⅰ以2 m·h-1的濾速啟動運(yùn)行,即是為了減小水流沖刷對馴化初期濾層間隙及濾料表面微生物菌群的影響,本試驗微生物馴化培養(yǎng)與裝置運(yùn)行同步進(jìn)行,因未研究馴化階段濾料上微生物數(shù)量隨時間增長變化關(guān)系,無法明確判斷濾料是否成熟,但可發(fā)現(xiàn)當(dāng)進(jìn)水水力負(fù)荷達(dá)到設(shè)計值(濾速控制在5 m·h-1)時,一定數(shù)量的優(yōu)勢鐵錳氧化菌可見,且濾層除鐵錳能力增強(qiáng),此時可認(rèn)定馴化培養(yǎng)工作完成.
2.1.1 培養(yǎng)期濾柱Ⅰ、Ⅱ出水Fe2+、Mn2+去除效果
濾柱Ⅰ除鐵效果如圖 3(a)所示,前4 d出水Fe2+波動幅度大、 去除率低且出水不達(dá)標(biāo),這是由于接種菌株在濾料表面附著松散且處于環(huán)境適應(yīng)階段,鐵菌催化氧化Fe2+能力有限; 第5~8 d,F(xiàn)e2+去除率持續(xù)上升,即便第7 d濾速由2 m·h-1增至3 m·h-1,出水Fe2+波動幅度仍逐漸減小,這可能由于Fe2+除生物氧化去除外,DO充足(4~5 mg·L-1)時還依靠化學(xué)氧化所致.濾柱Ⅰ除錳效果如圖 3(b)所示,前6 d濾柱Ⅰ對Mn2+的去除率逐漸升高,由7%增至91%,但出水Mn2+濃度均高于0.1 mg·L-1; 第7d、 13 d濾速改變時,Mn2+去除率均驟降,7~14 d出水Mn2+濃度波動幅度較大,第15 d后出水Mn2+濃度均低于0.1mg·L-1,去除率均在90%以上,該效果較Fe2+出現(xiàn)的晚8 d,這與Fu等和Phatai等[10]的結(jié)論一致,這是由于Fe2+作為菌的基礎(chǔ)代謝底物,為菌的生長繁殖提供了大部分的能量,而Mn2+的去除需菌具備較高活性且達(dá)到一定數(shù)量后才得以體現(xiàn).綜合出水Fe2+、 Mn2+去除效果,濾柱Ⅰ運(yùn)行15 d濾膜趨于成熟.濾柱Ⅱ除Fe2+、 Mn2+效果如圖 4所示,出水Fe2+、 Mn2+濃度均遠(yuǎn)低于0.1mg·L-1.

圖 3 濾柱Ⅰ 出水Fe2+、 Mn2+去除效果

圖 4 濾柱Ⅱ 出水Fe2+、 Mn2+去除效果
濾柱Ⅰ兩次啟動運(yùn)行15 d后,不斷提高濾速至5m·h-1,且停滯6 d再次低濾速啟動,出水Fe2+、 Mn2+濃度不受濾速改變、 停滯工況的影響,滿足《生活飲用水衛(wèi)生標(biāo)準(zhǔn)》(GB 5749-2006),且去除率均在90%以上,表明該試驗在低濾速條件下建立了穩(wěn)定的鐵錳優(yōu)勢菌種的微生態(tài)系統(tǒng),系統(tǒng)抗負(fù)荷、 抗沖擊能力較強(qiáng).
2.1.2 培養(yǎng)期濾柱Ⅱ出水細(xì)菌的去除情況
濾柱Ⅱ除鐵錳氧化菌效果如圖 5所示.

圖 5 濾柱Ⅱ 出水鐵錳氧化菌去除效果
由圖 5可知,培養(yǎng)初期濾柱Ⅰ內(nèi)濾膜不成熟,濾料表面菌附著力差,致使濾柱Ⅱ進(jìn)水細(xì)菌量高達(dá)482 CFU·mL-1; 隨著濾柱Ⅰ濾膜趨于成熟,進(jìn)入濾柱Ⅱ的細(xì)菌量逐漸降低,但水力條件的提升使濾柱Ⅱ進(jìn)水細(xì)菌量突增; 濾速由2 m·h-1增至3 m·h-1后,進(jìn)水細(xì)菌量增加93 CFU·mL-1(338~441 CFU·mL-1); 濾速增至4 m·h-1后,進(jìn)水細(xì)菌量增加64 CFU·mL-1(232~296 CFU·mL-1); 濾速增至5 m·h-1后,進(jìn)水細(xì)菌量僅增加21 CFU·mL-1,表明濾柱Ⅰ內(nèi)濾膜抗沖擊力強(qiáng),已趨于成熟.培養(yǎng)期濾柱Ⅱ出水細(xì)菌量始終低于100 CFU·mL-1,均達(dá)飲用水標(biāo)準(zhǔn),這可能由于載銀活性炭顆粒吸附菌、 抑菌或殺菌作用所致; 此外,水中銀離子濃度一直未超標(biāo),表明選用的載銀活性炭顆粒抗銀流失性能強(qiáng)、 安全可靠.
2.1.3 穩(wěn)定階段濾柱Ⅰ、 Ⅱ出水Fe2+、 Mn2+與細(xì)菌的去除情況
進(jìn)入穩(wěn)定階段,鐵、 錳、 細(xì)菌濃度均達(dá)到國家標(biāo)準(zhǔn),始終低于0.3 mg·L-1、 0.1 mg·L-1與100 CFU·mL-1.
2.2 生物濾層內(nèi)鐵氧化去除機(jī)制
基于接觸氧化法與生物法,對比分析不同濾速時濾柱Ⅰ沿程出水的總鐵、 Fe2+濃度及反應(yīng)速率,研究生物濾層除鐵機(jī)制,結(jié)果見圖 6、7.

圖 6 不同濾速、 進(jìn)水總鐵濃度條件下濾柱Ⅰ 中總鐵去除效果

圖 7 不同濾速、 進(jìn)水總鐵濃度條件下濾柱Ⅰ 中Fe2+去除效果
2.2.1 進(jìn)水總鐵濃度對去除效果影響分析
針對濾柱Ⅰ相同濾速、 不同進(jìn)水總鐵濃度的試驗結(jié)果,由圖 6可知,濾層深度120 cm范圍內(nèi),生物法出水總鐵濃度一般低于接觸氧化法,表明除鐵過程存在生物作用; 偶爾接觸氧化法除鐵效果更佳但差別不明顯,這可能受反沖洗等因素影響或某處濾層鐵氧化菌少所致.由圖 7可知,生物法與接觸氧化法對應(yīng)的出水除Fe2+效果差別不大,但生物法的除鐵速率均高于接觸氧化法,20 cm處的濾層對Fe2+的生物氧化率超過75%,而對Fe2+的接觸氧化率僅為20%~50%,這可能由于濾柱上部富氧,鐵氧化菌在有氧條件下可利用Fe2+作為電子供體為自身提供能量,強(qiáng)力促進(jìn)Fe2+氧化.
2.2.2 不同濾速對濾柱Ⅰ中鐵去除效果影響分析
針對濾柱Ⅰ不同濾速、 進(jìn)水總鐵濃度的試驗結(jié)果,生物法除總鐵、 Fe2+能力均高于接觸氧化法,受濾速的影響較大,且進(jìn)水總鐵濃度越低,濾速影響越顯著.由圖 6可知,接觸氧化法對于總鐵的去除效果相差不大,而在生物法中,濾層上部20 cm范圍內(nèi)低濾速對應(yīng)的濾柱沿程出水總鐵濃度略低,濾層中部(40~100 cm)高濾速對應(yīng)的濾柱沿程出水總鐵濃度略低,除總鐵能力差別明顯.由圖 7可知,濾層上部40 cm范圍內(nèi),不同濾速時接觸氧化法除Fe2+效果差別不大,生物法除Fe2+效果隨著濾速增加略有下降; 對于相同濾層深度,高濾速出水Fe2+濃度較低濾速的高,表明提高濾速后生物法需更大的濾層深度氧化Fe2+.當(dāng)進(jìn)水總鐵濃度大于5 mg·L-1時,濾層深度大于60 cm后,兩種方法出水Fe2+濃度幾乎不受濾速影響且均至去除極限,表明Fe2+去除主要集中于濾層上部60 cm范圍內(nèi).
綜上,除鐵機(jī)制主要是物化作用,輔以生物作用,鐵氧化菌促進(jìn)了Fe2+的氧化速率,增強(qiáng)了微生物對濾層截留鐵氧化物的能力; 濾速是影響生物除Fe2+能力的關(guān)鍵因素,該結(jié)論與文獻(xiàn)研究結(jié)果一致.
2.3 生物濾層內(nèi)錳氧化去除機(jī)制 2.3.1 濾柱啟動后培養(yǎng)初期成熟濾料表征
(1) 微生物形態(tài)分析
裝置運(yùn)行第16 d時,濾柱Ⅰ、 濾柱Ⅱ成熟濾料表面與反沖洗水中泥樣的微生物形態(tài)如圖 8所示.
![]()
圖 8 濾柱Ⅰ、 濾柱Ⅱ 濾料與反沖洗泥樣的微生物SEM圖
圖 8(a)與圖 8(b)中均存在大量的細(xì)菌與片層狀或顆粒結(jié)構(gòu),其在反沖洗水中的量較大,該微生物可能主要為接入的原始Bacillus megaterium菌群,其依靠進(jìn)水中鐵、 錳等地下水自身營養(yǎng),經(jīng)適應(yīng)期對數(shù)生長期培養(yǎng)后占據(jù)生態(tài)位的主體,后續(xù)應(yīng)采取分子生物學(xué)手段進(jìn)一步確認(rèn)細(xì)菌的種類; 片層狀或顆粒結(jié)構(gòu)可能為Bacillus megaterium菌的代謝產(chǎn)物及截留吸附物.由圖 8(c) 與圖 8(d)可知,濾柱Ⅱ成熟濾料表面與反沖洗水Bacillus megaterium菌的數(shù)量較少,這表明濾柱Ⅰ濾料表面形成的生物除鐵錳活性濾膜成熟且穩(wěn)定.
(2) 濾料表面物質(zhì)分析
為進(jìn)一步確定濾料表面附著的片層狀或顆粒結(jié)構(gòu)物質(zhì),采用FTIR對成熟濾料進(jìn)行分析.原始碳化稻殼與濾層成熟濾料的FTIR如圖 9所示.從中可知,3 362 cm-1處吸收峰表明了OH-存在,1 618 cm-1與1 398 cm-1處吸收峰表明了有機(jī)物的存在,因進(jìn)水(配水)中幾乎不存在有機(jī)物,故此處的有機(jī)物即代表微生物; 698 cm-1處吸收峰表明了Si—C的存在,這是由于碳化稻殼本身成分所致; 970 cm-1處出現(xiàn)了α-FeOOH 的特征吸收峰; 583 cm-1處出現(xiàn)了 Mn—O的特征吸收峰. 由此可見,成熟濾料存在大量的微生物與鐵、 錳氧化物.

圖 9 碳化稻殼與成熟濾料的FTIR圖譜
(3) 濾料表面元素價態(tài)分析
為進(jìn)一步研究生物除鐵除錳過程中鐵、 錳的去除機(jī)制以及非液相產(chǎn)物上鐵、 錳的價態(tài)組成,本試驗采用XPS對反沖洗泥樣進(jìn)行分析,結(jié)果見圖 10.

圖 10 反沖洗泥樣的XPS分析圖譜
圖 10分別為C1s、 O1s、 Mn2p、 Fe2p的XPS光譜圖,通過找到峰值處所對應(yīng)的橫坐標(biāo)結(jié)合能(binding energy)來判定是否存在某種元素及該元素的存在形式.從圖 10(a)可知,C1s的出峰位置在284.6 eV及288.5 eV處,分別表明樣品中存在C—C、 C—H鍵與酯類官能團(tuán),因酯類化合物為微生物生長所需且為微生物氧化產(chǎn)物的重要組成部分,故表明樣品中存在微生物.從圖 10(b)可知,O1s的出峰位置在529.7 eV及530.7 eV處,分別表明樣品中存在晶格氧O2-、 醇羥基OH-,O2-的出現(xiàn)通常為氧與金屬元素的結(jié)合,進(jìn)而證明了鐵錳氧化物的存在,后者則表明樣品表面存在OH-吸附情況.從圖 10(c)可知,Mn2p3/2峰值出現(xiàn)在641.9 eV.錳在反應(yīng)器中一般以多種價態(tài)形式存在,通常用MnOx來表示錳的化學(xué)結(jié)構(gòu): 當(dāng)x為1、 2時,錳的化合價分別為+2、+4,對應(yīng)峰值在640.6eV、 642.2eV處; 錳還可以+3價存在,如MnOOH,出峰位置為641.5eV.因本研究的Mn2p3/2結(jié)合能為641.9eV在641.5 eV與642.2 eV之間,故認(rèn)為MnOx中Mn的平均價態(tài)在+3與+4之間.從圖 10(d)可知,F(xiàn)e2p3/2的出峰位置在711.6 eV處,該處是鐵羥基氧化物的特征峰,該氧化物一般存在于針鐵礦或水鐵礦中; Søgaard等研究表明針鐵礦或水鐵礦峰值分別為711.9 eV與711.6 eV,可確定樣品表面存在的羥基氧化物是無定型的水鐵礦,這與Katsoyiannis等的生物除鐵研究結(jié)果一致.
(4) MnOx物相分析
經(jīng)歷不同運(yùn)行時間的濾料的Raman光譜分析見圖 11.從中可知,濾料成熟初期,Raman光譜主要有 3個峰,Raman 位移分別為503、 576和669 cm-1,表明錳氧化物為水鈉錳礦(birnessite)型,運(yùn)行時間越長,水鈉錳礦峰值強(qiáng)度減弱,此時水鈉錳礦的結(jié)晶度很低或呈無定形相.

圖 11 不同運(yùn)行時間的濾料表面錳氧化物的Raman光譜
2.3.2 濾柱除錳機(jī)制分析
Kim 等[23]采用EPR光譜區(qū)分17℃ 溫度下水鈉錳礦生物或無機(jī)(非生物)作用形成機(jī)制: 當(dāng)光譜波長ΔH為(600~1 200)×10-4 T(高斯)時,除錳機(jī)制主要是生物作用,ΔH大于1 200×10-4 T時,主要依靠非生物作用除錳.
自濾柱成功啟動(15 d)后對不同運(yùn)行時間的濾料表面與反沖洗水泥樣中的水鈉錳礦進(jìn)行EPR光譜分析,結(jié)果見圖 12.

圖 12 不同運(yùn)行時間時濾料表面與反沖洗泥樣中水鈉錳礦EPR光譜波長ΔH
由圖 12可知,隨著運(yùn)行時間的延長,濾料表面水鈉錳礦的ΔH值也隨之增加,250 d內(nèi),ΔH值增加快速,當(dāng)400 d后,ΔH從(600~1 200)×10-4 T范圍變化升至1 200×10-4 T以上,表明400 d后除錳機(jī)制從生物作用轉(zhuǎn)變?yōu)槲锘饔茫锘饔弥饕獮榉磻?yīng)速度極快的自催化氧化.反沖洗水中水鈉錳礦的ΔH值圍繞600×10-4 T上下波動,表明生物除錳存在于整個過濾過程,此處的水鈉錳礦主要是生物作用形成,來自濾料生物膜表面,易被水沖刷.試驗過程中濾柱膨脹幅度低,表明物化形成的水鈉錳礦緊固濾料表面,極少被沖刷.
檢驗生物作用與物理化學(xué)作用形成水鈉錳礦的結(jié)構(gòu)差異,不同運(yùn)行時間濾料表面水鈉錳礦的SEM分析見圖 13.

圖 13 不同運(yùn)行時間濾料表面水鈉錳礦的SEM 圖
由圖 13可知,生物作用形成的水鈉錳礦呈蓬松的板結(jié)構(gòu); 物理化學(xué)作用形成的水鈉錳礦呈珊瑚或海綿狀結(jié)構(gòu),Post指出水鈉錳礦由八面體MnO6層堆疊而成,層間充滿陽離子和水,該結(jié)構(gòu)特征易參與氧化、 陽離子交換反應(yīng),這表明水鈉錳礦自催化氧化能力強(qiáng).SEM也證實,水鈉錳礦是結(jié)晶或無定形的.
綜上所述,在濾料成熟階段與穩(wěn)定運(yùn)行初期主要依靠的是生物作用,穩(wěn)定運(yùn)行后期物理化學(xué)作用占優(yōu)勢.具體參見污水寶商城資料或http://www.bnynw.com更多相關(guān)技術(shù)文檔。
3 結(jié)論
(1) 生物濾柱Ⅰ耦合碳化稻殼與優(yōu)勢鐵錳氧化菌,采用全循環(huán)、 低濾速方式實現(xiàn)15 d快速啟動濾柱,運(yùn)行中逐漸提升濾速與反沖洗強(qiáng)度順應(yīng)實際需求,濾柱Ⅱ以載銀活性炭顆粒去除濾柱Ⅰ出水殘余菌,濾柱Ⅰ穩(wěn)定階段鐵、 錳的平均去除率為98.99%、 93.92%,平均出水濃度為0.105 mg·L-1、 0.727 mg·L-1; 濾柱Ⅱ穩(wěn)定階段鐵、 錳、 細(xì)菌的平均去除率為91.87%、 82.76%、 91.14%,平均出水濃度為0.009 mg·L-1、 0.012 mg·L-1、 13 CFU·mL-1; 兩濾柱出水均達(dá)到國家生活飲用水衛(wèi)生標(biāo)準(zhǔn)(GB 5749-2006).
(2) 除鐵機(jī)制主要為物化作用,輔以生物作用,鐵氧化菌促進(jìn)了Fe2+的氧化速率,增強(qiáng)了微生物對濾層截留鐵氧化物的能力; 濾速是影響生物除Fe2+能力的關(guān)鍵因素.
(3) SEM、 FTIR與XPS分析表明成熟濾料存在大量的微生物與鐵、 錳氧化物; MnOx中Mn的平均價態(tài)在+3與+4之間; Raman光譜分析進(jìn)一步明確了MnOx為水鈉錳礦(birnessite).EPR光譜與SEM分析推斷在濾料成熟階段與穩(wěn)定運(yùn)行初期除錳主要依靠生物作用、 穩(wěn)定運(yùn)行后期物理化學(xué)作用占優(yōu)勢.


